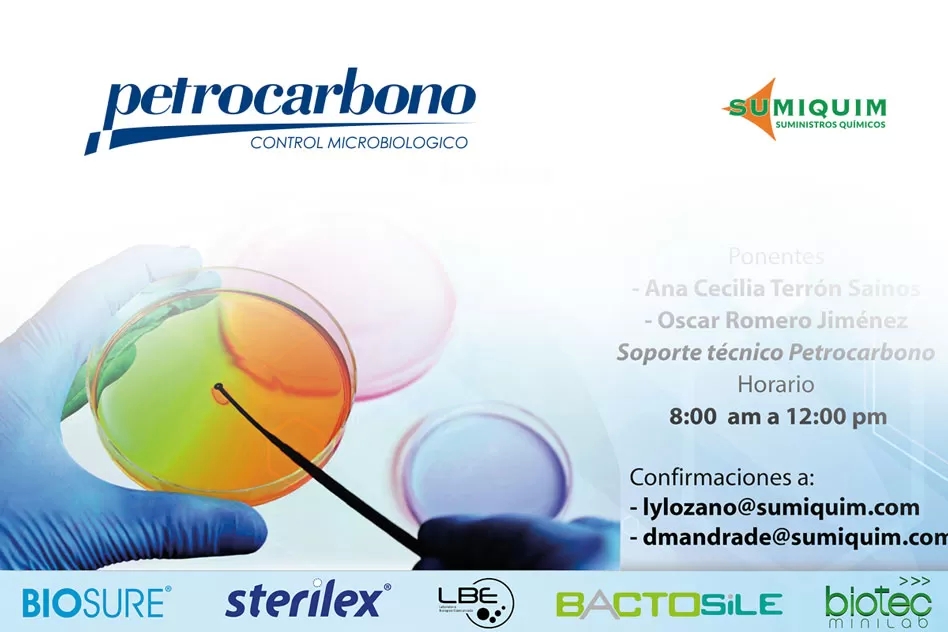

Es un gusto para Suministros Químicos. Sumiquim poder invitarlos al Workshop especializado en control microbiológico que realizaremos este mes de Febrero en tres ciudades (Medellín – Bogotá y Cali), con nuestro representado Petrocarbono de México, proveedor de soluciones integrales para el control microbiológico industrial. Completamente gratuito. Sólo requerimos su confirmación.